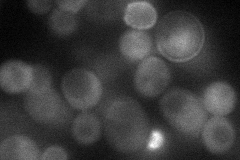
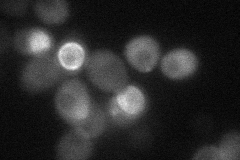
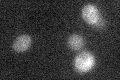

View description
Protein similar to GDP/GTP exchange factors but without detectable GEF activity; required for asymmetric localization of Bfa1p at daughter-directed spindle pole bodies and for mitotic exit at low temperatures
Localization:
Intensity:
Fold change:
Significance:
-
C’ GFP library in SD

bud22.07 -
N' NOP1pr-GFP in SD
bud34.5957 -
N' TEF2pr-mCherry in SD
below threshold32.6133 -
N' NATIVEpr-GFP in SD

punctate18.2065 -
N' TEF2pr-VC and Cyto-VN in SD

bud32.0157 -
C’ GFP library in SD+DTT

budN/AN/ANo -
C’ GFP library in SD+H2O2

bud.cytosolN/AN/ANo -
C’ GFP library in Starvation Media
cytosolN/AN/AYes -
C’ GFP library on the background of Pup2-DaMP

bud -
C’ GFP library on the background of CCT mutant

budN/AN/ANo
